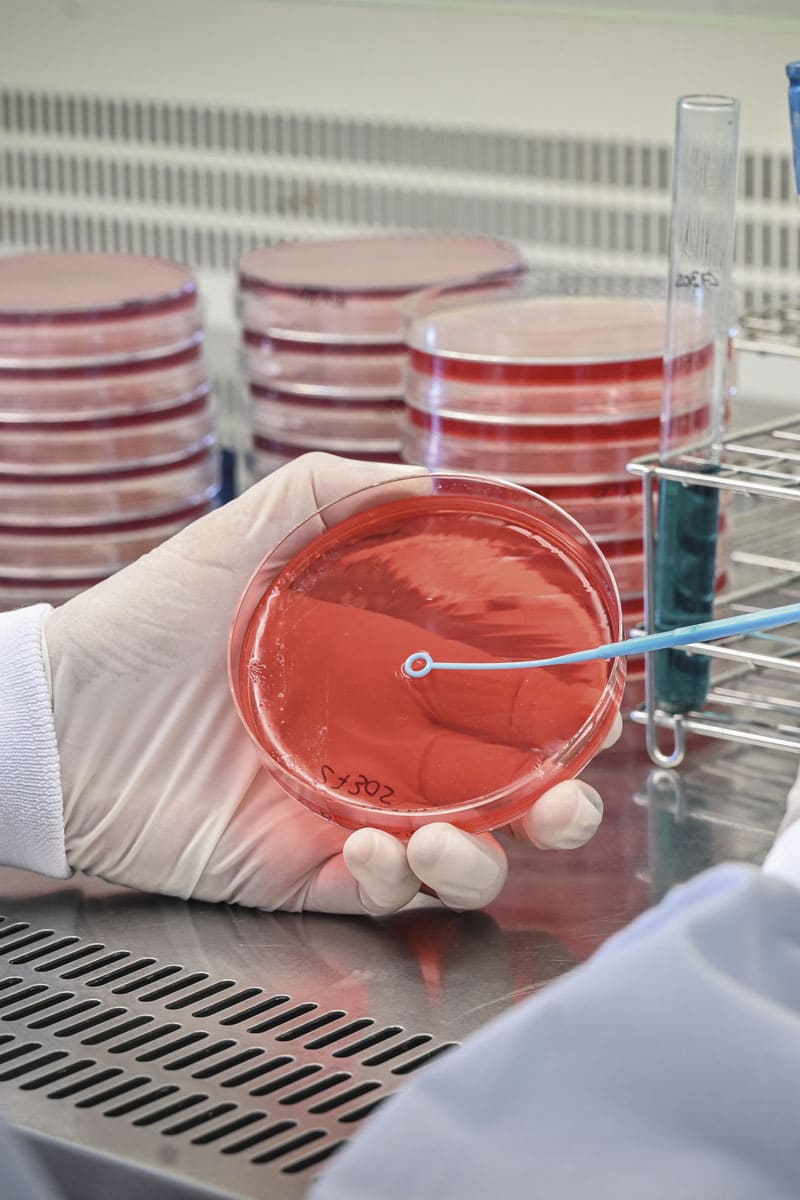

Análisis microbiológico
La identificación de microorganismos puede resultar imprescindible en diferentes casos:
Hasta la introducción de la EM MALDI-TOF, la identificación bacteriana seguía nutriéndose de los métodos desarrollados por la bacteriología clásica. Estos métodos presentaban toda una serie de inconvenientes entre los que destaca la necesidad, en la mayoría de los casos, de periodos de incubación de al menos 16-18h, además de otros inconvenientes de índole técnica.
Frente a estos métodos clásicos de identificación, la EM MALDI-TOF tiene ventajas evidentes:
Nuestras soluciones incluyen:
| Responsable | AINIA |
| Domicilio | Calle Benjamín Franklin, 5 a 11, CP 46980 Paterna (Valencia) |
| Finalidad | Atender, registrar y contactarle para resolver la solicitud que nos realice mediante este formulario de contacto |
| Legitimación | Sus datos serán tratados solo con su consentimiento, al marcar la casilla mostrada en este formulario |
| Destinatarios | Sus datos no serán cedidos a terceros |
| Derechos | Tiene derecho a solicitarnos acceder a sus datos, corregirlos o eliminarlos, también puede solicitarnos limitar su tratamiento, oponerse a ello y a la portabilidad de sus datos, dirigiéndose a nuestra dirección postal o a privacy@ainia.es |
| Más info | Dispone de más información en nuestra Política de Privacidad |
| DPD | Si tiene dudas sobre como trataremos sus datos o quiere trasladar alguna sugerencia o queja, contacte al Delegado de protección de datos en info@businessadapter.es o en el Formulario de atención al interesado |
Consiento el uso de mis datos personales para que atiendan mi solicitud, según lo establecido en su Política de Privacidad.
Consiento el uso de mis datos para recibir información y comunicaciones comerciales de su entidad.
